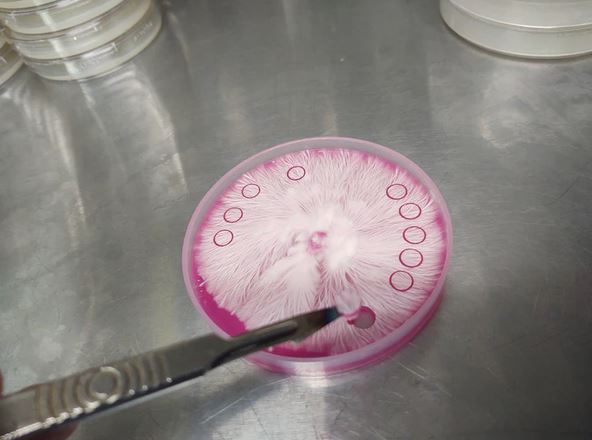
Sterile 6mm Agar Punches (2-Pack)

Sterile 6mm Agar Punches (2-Pack)
Sterile 6mm Agar Punches (2-Pack) is backordered and will ship as soon as it is back in stock.
Couldn't load pickup availability
Description
Description
Sterile 6mm Agar Punches (2-Pack)
Precision Tools for Mycology, Cloning & Lab Work
These professional-grade 6mm Agar Punches are the ideal tool for precise agar transfers, cloning, and lab work. Each unit is individually wrapped and sterile, built with a tempered stainless-steel blade and durable plastic handle for long-term use and superior control.
Perfectly sized for isolating healthy mycelium, the 6mm punch creates uniform circular samples that promote even radial growth on agar. Whether you're isolating cultures or performing transfers, this tool is engineered for accuracy, hygiene, and ease of use.
Includes:
- (2) Sterile 6mm Agar Punches
- Individually sealed and ready to use
- Tempered stainless-steel construction
- Ergonomic plastic handle for a secure grip
- Reusable when sterilized with isopropyl alcohol
- Bonus cosmetic applications: skin tag, callus, and dead skin removal
Designed for clean-room work and field lab conditions, these punches are a must-have for any serious mycology setup.